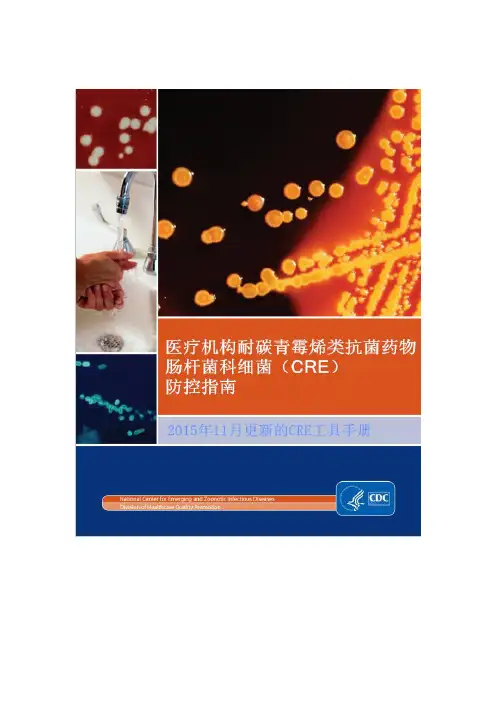

美国行为危险因素监测系统简述
- 格式:pdf
- 大小:290.27 KB
- 文档页数:4


一、填空题1、体育(广义)是指以身体练习为基本手段,为增强体质提高运动技术水平,进行思想品德教育,丰富社会文化生活而进行的一种有意识的身体运动和体育运动。
2、根据《学生体质健康标准》的要求,大学生需要完成六项指标的测试,分别是身高,体重,肺活量,台阶测试,50米跑或立定跳远,握力或仰卧起坐或坐位体前屈。
3、健康不仅是没有疾病,二十指身体的,心理的,社会适应的良好状态。
4、现代体育的发展正日益改变着人类的生活方式和消费结构,促进了与运动训练,体育比赛有关的物质资料的生产和流通,以至于逐渐形成了规模宏大的体育产业系统。
5、今年我国广州举办了第16届亚洲运动会。
二、是非题1、体育作为一种特殊的社会现象,它以强化训练为基本手段,既是以增强体质,促进身体健康为目的的教育,又是社会文化活动的组成部分。
(T)2、社会体育开展的广泛性和社会化程度,取决于全民体育意识和群众体育组的提高. (F)3、我国高校体育的首要任务是造就骨干,指导普及.(T)4、大学生的主要心理特征,从以下四个方面明显地呈现出来:(一)自我意识方面;(二) 情感方面;(三)意志方面;(四)性格方面。
(F)5、糖是运动时的主要能量来源之一,一克糖完全氧化可以释放4。
1千卡的能量。
(T)6、体育课程是我国高校教学计划中的基本课程之一,是高校体育工作的中心环节,也是实现高校体育目的的唯一组织形式。
(F)7、1000米跑过程中能量代谢完全是有氧代谢。
(F)8、我国高校体育的目的是以身体练习为基本手段,培养学生的体育意识,增强体育能力,养成自觉锻炼身体的习惯,使之成为体魄强健的社会主义现代化事业的建设者和接班人。
(T)9、课外体育活动是高校体育课程的延续和补充,是实现高校体育目的的重要组织形式.《学校体育工作条例》规定:中等专业学校、普通高等学校除安排体育课、劳动课的当天外,每天应组织学生开展各种课外体育活动.(F)10、最大吸氧量是反映人体极量强度是的摄氧和耗氧能力,是心血管功能的最主要评价指标。


1、事故统计与分析P38它是以大量的伤亡事故资料为基础,应用数理统计的原理和方法、从宏观上探索伤亡事故发生原因及规律的过程。
2、事故事故是人们生产、生活的活动过程中,突然发生的、违反人的意志的、迫使活动暂时或永久性停止,可能造成人员伤害,财产损失或环境污染的意外事件。
3、海因里希法则美国人海因里希调查了55万多起伤害事故后发现,涉及同一工人的330件相似的意外事件中,有300起未产生伤害,29件产生轻、微伤,1次产生死亡,故也称300:29:1法则。
4、本质安全技术所谓本质安全技术,是指不是从外部采取附加的安全装置和设备,而是依靠自身的安全设计,进行本质方面的改善,即使发生故障或误操作,设备和系统仍能保证安全。
5、隔离隔离是采用物理分离、护板和栅栏等将已识别的危险同人员和设备隔开,以防止危险或将危险降低到最低水平,并控制危险的影响。
隔离是最常用的一种安全技术措施。
6、三同时建设项目中职业安全与卫生技术措施和设施主体工程同时设计、同时施工、同时投产使用。
习惯上称之为“三同时”。
7、三不放过事故原因分析不清不放过,事故责任者和群众没有受到教育不放过,没制定出防范措施不放过。
8、一遵二反三落实教育职工遵守劳动纪律;反对违章指挥、违章作业;监督与协助企业行政部门落实各级安全生产责任制,监督与协助企业行政部门落实预防伤亡事故的各种措施,组织落实人人为安全生产和劳动保护做一件好事活动。
9、安全目标管理安全目标管理是企业确定在一定时期内应该实现的安全生产总目标,分解展开,落实措施,严格考核,通过组织内部自我控制达到安全生产目的的一种安全管理方法。
10、化学事故由危险化学品所导致的火灾、爆炸、中毒和窒息事故可称为化学事故。
具体说来,由危险化学品引起的火灾、爆炸通常导致大量人员伤亡和财产损失,同时泄漏的危险化学品或火灾、爆炸的产物对大气、水源、土壤等造成污染,污染物经口、皮肤进入体内导致群体中毒、窒息甚至死亡,此类事故称之为化学事故。

美国2015年医疗机构CRE防控指南翻译:孔晓明、朱晓露校审:杨乐、廖丹前言该文件是在2012年版医疗机构CRE防控指南的进一步更新。
术语“医疗照护机构”是指所有的急症照护医院和提供长期照护的机构,患者住院并常规需要医疗或护理照护(如侵入性装置的留置、静脉注射、伤口护理等)。
这就意味着包括了所有提供长期急症照护的医院以及提供熟练照护或康复服务的养老院,但一般不包括辅助生活机构和不提供长期看护的养老院。
此外,该指南不适用于门诊照护机构。
耐药菌的防控是一个国家层面的问题,需要所有医疗机构携手阻止其传播。
这些工作最好在当地公共卫生部门的协调下开展。
强烈鼓励医疗机构参与区域内的耐药菌防控工作。
2015版与2012版工具手册相比有何不同?1.对CDC的CRE监测定义进行了修订。
2.单一干预层级取代了二级干预层级。
不是所有的干预措施都适用于所有的医疗机构或情形。
根据特定情形所传递出的讯息,制定针对性的干预措施才是最重要的。
3.深入讨论了在急症后期照护机构是否采用接触隔离措施。
4.为了让此版指南对医疗机构更具针对性,原来关于区域化干预措施的内容被删除。
协调各地区的方法,对于预防多重耐药菌感染来说仍然很重要;关于这些方式的其他内容将在另外的文件中叙述。
5.在干预措施中添加了医疗机构间沟通的部分。
背景CRE定义通常,CRE是对碳青霉烯类不敏感(中介或耐药)的肠杆菌科细菌。
然而,如上所述,肠杆菌科细菌对碳青霉烯类抗菌药物的不敏感性可以通过若干不同机制获得,碳青霉烯酶的产生是目前最令人关切的耐药机制。
由于2012年的CRE定义过于复杂而难以实施,为了简化CRE 定义以及进一步通过定义提高识别产碳青霉烯酶CRE的能力,CDC 已完善2012年中期CRE监测定义:CRE是肠杆菌科细菌,它们是:∙对任何碳青霉烯类抗菌药物耐药(即多利培南、美罗培南或亚胺培南最小抑制浓度(MIC)≥4mcg / ml,或厄他培南MIC≥2mcg / ml)或∙产碳青霉烯酶此外:∙对亚胺培南天然非敏感的细菌(即摩氏摩根氏菌、变形杆菌属、普罗威登斯菌属),需要对除亚胺培南以外的碳青霉烯类耐药。

题安全系统工程试一、填空题(30 分,每空 1.5 分)1、系统的属性主要包括:整体性、相关性、有序性、目的性等四个方面。
-机 -环境系统;主要研究内容包括系统安全分析;2、安全系统工程的研究对象是人系统安全评价;安全决策与事故控制等三方面。
C CA 表示原因-后果分析法;FMEA 表3、在安全系统工程学分析方法中,通常示故障类型和影响分析;ETA 表示—事件树分析;FTA 表示事故树分析;HAZOP 表示危险性和可操作性研究。
能4、可靠度是指系统、设备或元件等在规定时间和规定的条件下,完成规定功的能力。
5、系统是由相互作用和相互依赖的若干组成部分结合成的具有特定功能的有机整体。
协会规6、DOW 化学火灾爆炸指数评价法中物质系数是根据由美国消防定的可燃性N f 和化学活性N r 求取的。
7、PHA 方法包括:准备、审查、结果汇总三个阶。
段二、判断题(20 分,正确的划√,错误的划X,每题答对得2分,答错扣 2 分)1、弹性原理不属于系统工程原理。
(√)2、串联系统的失效概率等于各子系统失效概率的积。
(×)3、定性方法和定量方法的合理结合是分析系统安全性的有效途径。
(√)4、安全系统工程是在事故逼迫下产生的。
(×)5、FTA 方法既可用作定性分析,又能进行定量分析。
(√)6、安全系统工程中最基本、最初步的一种形式是SCL(安全检查表)。
(√)7、能量原理是安全评价的基本原理。
(×)8、最小径集是保证顶上事件不发生的必要条件。
(√)9、ICI MOND 法和DOW 化指数法的原理相同。
(√)10、回归分析法是一种代表性的时间序列预测法。
(√)三、计算题(40 分)1、并联系统有n 个子系统,可靠度值分别为R1,R2,⋯⋯,R n,推导该并联系统的可靠度表达式;(5 分)n系统的故障概率为:P= (1 )Rii 1n所以系统的可靠度为:R=1-P=1- (1 )Rii 12、计算如下图所示的泵、阀门输送系统失败的概率:(5 分)失败的概率为P=1-A1B1C1=1-0.7695=0.23053、某事故树如下图所示,X1,X2,X3,X4 ,X5 均为基本事件,其概率分别为0.01,0.02,0.03,0.04,0.05,求顶上事件发生的概率(10 分)和各基本事件的概率重要度(10 分)、临界重要度(10 分)。

健康管理师专业技能笔试2021一、某市某社区,常住人口7414人,外来人口731人。
社区内60岁以上老人1191人〔占16%〕。
该社区有7名卫生效劳人员〔2名全科医生,2名护士,2名助理医生和1 名公共卫生人员〕。
2021年该社区卫生效劳站开始责任医生进家庭的试点工作,并开展社区慢性病管理工作。
根据以上情况,答复以下问题。
〔此题总分25分〕 1.假设在该社区开展健康信息的收集工作,其根本步骤包括哪几方面?〔7〕2.社区慢性病管理所使用的健康调查表一般包括哪些内容。
〔7〕3.如何识别不合逻辑的健康信息记录?〔6〕4.对于已收集的健康相关信息。
从哪几方面进行信息管理?〔5〕参考答案:1、〔1〕收集资料前准备;〔2〕明确调查对象;〔3〕签署之情同意书;〔4〕开始调查;〔5〕记录表的核查;〔6〕结束访谈;〔7〕资料的保存。
2、〔1〕根本信息:工作单位、联系人姓名、名族、血型、文化程度、药物过敏史、既往史和家族史;〔2〕生活方式信息:烟草使用、饮酒情况、膳食状况以及身体活动;3、〔1〕通过其他人重新输入数据来检查错误〔即双份录入〕或是通过专人来检查过失;〔2〕目测检查数据文件中的记录是否存在相同的格式,是否能发现空白数据;〔3〕应用计算机查错:一是在数据库设计阶段,确定每一个变量特定范围内的编码来确定其属性,以规定接受合理的编码。
二是应用逻辑检查的方法进行查错,通过应用反证法程序,以检查特定问题和其他问题的答复是否存在逻辑上的合理性。
4、〔1〕数据核查,第一步是运行统计软件的根本统计量过程,列出每个变量的最大值和最小值,如果某变量的最大值或最小值不符合逻辑,说明数据有误;第二步进行数据核对;〔2〕信息整理:第一步是根据信息资料的性质、内容或特征进行分类;第二步是进行资料汇编;第三步是进行资料分析。
〔3〕信息更新。
二、张先生,50岁,25年吸烟史,本人无糖尿病,血压150/90mmHg,体质指数25,总胆固醇5.46mmol/L。

CATI在美国行为危险因素监测中的应用(BRFSS)美国行为危险因素监测系统(BRFSS)就是在这样的背景下于上世纪80年代中期正式建立的(CDC 1984)。
当时只有15个州参与,内容主要是个人高危行为。
其主要目标是各州通过收集、分析和利用本地行为危险因素和卫生实践的相关资料,服务于干预项目、公共卫生立法以及相应社会政策的制订。
从80年代后期开始监测的内容不断扩大,逐渐增加各州自己感兴趣的特殊问题,以及胆固醇筛检,乳房X线照像等内容。
这项监测在美国开展20余年,由最初的一个慢性病一级预防计划和研究设想,发展成在部分地区实施的试验性监测,最后扩大成为覆盖美国本土所有的50个州以及哥伦比亚特区、关岛、波多黎各和美属维京群岛的监测系统(CDC 1996)。
该系统以计算机辅助电话调查系统为依托,以州为单位搜集数据,CDC提供监测的技术支持和负责组织实施,监测的最终指向目标包括成年人慢性病和伤害控制和可以预防的感染性疾病(preventable infectious diseases)[2]。
20余年的连续监测使CDC获得了和行为危险因素流行状况相关的,极其丰富翔实的一手资料。
由于数据的高度共享性、连续性、完整性,方法学的不断进步,监测资料也成为了公共卫生官员和学者进行相关研究的有力工具,特别在对比历史数据、分析公共卫生措施的效益、寻找重要公共卫生问题方面发挥了巨大的作用[3]。
从美国的公共卫生政策层面看,人群高危行为危险因素的预防和控制已经成为2010年全国健康主要指标(Leading Health Indicators)中的重中之重。
这些主要的指标是:体力活动,超重和肥胖,吸烟,酗酒,药物滥用,负责任的性行为,精神卫生,伤害和暴力,环境质量,免疫,和卫生服务的可及性。
2003年底美国CDC公布的2004年度监测计划基本上覆盖了上述所有的指标领域。
因此,这一监测系统可以说是一个目标明确并具有相当弹性和敏感性的危险因素监测系统。

临床科室医院感染控制情况风险评估科室:评估日期:年月日每题得1分。
高风险≥6分,中风险4~5分,低风险≤3分ICU感染风险因素评估手术室医院感染危险因素评估评估日期:评估者:科室负责人:新生儿室感染风险因素评估产房感染风险因素评估普通病区重点环节、重点人群、高危因素评估清单儿、外病区重点环节、重点人群、高危因素评估清单ICU病区重点环节、重点人群、高危因素评估清单产房重点环节、重点人群、高危因素评估清单手术室重点环节、重点人群、高危因素评估清单昌江黎族县人民医院重点环节、重点人群与高危险因素管理与监测计划认真贯彻落实《医院感染管理办法》,严格执行有关医院感染控制的技术和标准,加强医院感染管理工作,医院感染管理部门及各相关科室应当高度重视对重点环节、重点人群与高危险因素的预防与控制工作,强化安全意识,明确并落实各部门在医院感染预防和控制工作中的职责,加强监管力度。
针对医院感染的易感特点及医院感染预防与控制的各个环节,制定并完善相应的规章制度和工作规范,切实从管理及技术等方面采取有效措施,降低医院感染发生率。
一、加强对重症监护病房(ICU)、手术室、新生儿室、血液透析室、内镜诊疗中心(室)、消毒供应中心等医院感染重点部门的管理。
贯彻落实《重症医学科建设与管理指南(试行)》、《医院手术部(室)管理规范(试行)》、《新生儿病室建设与管理指南(试行)》、《医疗机构血液透析室管理规范》、《医院消毒供应中心管理规范》等有关技术规范和标准,健全规章制度、细化工作流程、落实各项措施。
1、开展重症监护病人、新生儿病室、手术部位综合性目标性监测,重点关注留置中心静脉导管、导尿管、使用呼吸机和特殊手术的患者(如:出血量多、污染伤口等)的患者。
2、对开展目标性监测的科室,院感专职人员定期下临床科室督查,进行现场指导,定期对重点部门进行环境卫生学监测,加强监督。
3、加强对重点部门环境卫生学监测。
每季度对重症监护病房(ICU)、手术室、新生儿室、血液透析室、内镜室、消毒供应中心等重点部门进行环境卫生学监测,保持环境清洁卫生,符合要求。
ICS ××××××× × ××备案号:×××-××××中华人民共和国卫生行业标准HRB03.11行为危险因素监测基本数据集Basic dataset of behavioral risk monitoring中华人民共和国卫生部WS D00X-2009目次前言................................................................................ I I1 范围 (1)2 规范性引用文件 (1)3 术语和缩略语 (1)3.1 术语 (1)3.2 缩略语 (2)4 数据集元数据 (2)5 数据元目录 (2)5.1 数据元属性 (2)5.2 数据元值域代码表 (7)6 数据元索引 (9)WS D00X-2009前言《行为危险因素监测基本数据集》是我国居民健康档案卫生服务基本数据集标准的组成部分之一。
本标准旨在为行为危险因素监测信息提供一套术语规范、定义明确、语义语境无歧义的基本数据集标准,以规范行为危险因素监测基本记录内容,实现行为危险因素监测信息在收集、存储、发布、交换等应用中的一致性和可比性,保证行为危险因素监测信息的有效交换、统计和共享。
本标准以行为危险因素监测记录表中各记录项为对象,以数据元为标识单元,按照摘要式目录格式编制。
包含38个数据元,8个数据元值域代码表。
本标准由中华人民共和国卫生部卫生信息标准专业委员会提出;本标准由中华人民共和国卫生部归口;本标准负责起草单位:上海市疾病预防控制中心;本标准的主要起草人:WS D00X-2009行为危险因素监测基本数据集1 范围本标准规定了行为危险因素监测基本数据集的内容范围、分类编码和数据元及其值域代码标准。